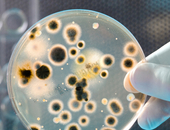

Implementa un control de alérgenos en tu planta, aprende por qué son tan importantes los análisis microbiológicos, y otros temas de interés, en el módulo 3 de nuestro diplomado en línea.
Inicia: 22 Julio
Sesiones: Martes y Jueves
Horario:8:00 a 9:30 am (hora del centro de México)
Duración del módulo:10 sesiones de 1.5 horas cada una